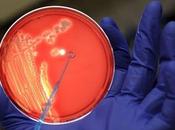
¿Qué Coli"?

Ana46
 Descripción
Descripción
He creado este blog con la intención de que las personas con una enfermedad crónica como la mía sepan que se puede tener una buena calidad de vida y sentirnos bien con nosotros mismos y con nuestro aspecto.También podeis visitarlo aunque no tengais ninguna enfermedad, pues hablo de todo para tener una buena calidad de vida en general.
compartido
MIS BLOGS
-
Vivir con insuficiencia renal
http://www.vivirconinsuficienciarenal.com/
He creado este blog con la intención de que las personas con una enfermedad crónica como la mía sepan que se puede tener una buena calidad de vida y sentirnos bien con nosotros mismos y con nuestro aspecto.También podeis visitarlo aunque no tengais ninguna enfermedad, pues hablo de todo para tener una buena calidad de vida en general.
ÚLTIMOS ARTÍCULOS (822)
-
Alcer dice que la diálisis peritoneal facilita mantener el trabajo

Juan Carlos Julián, coordinador de la federación nacional ALCER ha dicho hoy a Efe que la diálisis peritoneal es una opción tan buena como la hemodiálisis, y... Leer el resto
Publicado el 14 junio 2011 SALUD Y BIENESTAR -
Campaña de donación de Organos

Campaña de donación de órganos. En autobuses de línea de Alicante (lineas 24 y 21) durante el mes de junio 2011 Ana Hidalgo Leer el resto
Publicado el 13 junio 2011 SALUD Y BIENESTAR -
Peras al vino y Gelatina de frutas

Peras al vino Ingredientes: Peras Azúcar Canela en rama Vino Agua Preparación: Se colocan las peras enteras pero peladas en una cazuela cubiertas por el vino,... Leer el resto
Publicado el 11 junio 2011 SALUD Y BIENESTAR -
Los tacones altos

Muchas veces nos cuesta resistirnos a un bonito zapato de tacón alto, tan de moda en estos días. Pero es conveniente saber qué consecuencias tiene abusar de est... Leer el resto
Publicado el 10 junio 2011 SALUD Y BIENESTAR -
Mejorar la higiene en la cocina

■Cómo incorporar a tu rutina habitual sencillas y rápidas medidas de limpieza. ■De ese modo, lo que consumas en tu casa estará libre de cualquier... Leer el resto
Publicado el 09 junio 2011 SALUD Y BIENESTAR -
Imagen corporal en los enfermos crónicos

Hoy hablando con una monitora nueva del gimnasio, y comentándole que estaba trasplantada, se ha quedado sorprendida de que tuviera tan buen aspecto. Creo que la... Leer el resto
Publicado el 08 junio 2011 SALUD Y BIENESTAR -
Rumbo al Mundial de trasplantados

Javier Gracia PINA DE EBRO Javier Gracia participará en la cita de Suecia El próximo 17 de junio, el pinero Javier Gracia partirá hacia Suecia. Será el único... Leer el resto
Publicado el 08 junio 2011 SALUD Y BIENESTAR -
«Hay que convivir con la diabetes, no vivir para ella»

Manuel Botana desarrolla su labor en el hospital Lucus Agusti Preside la sociedad gallega de endocrinología El especialista explicó qué cuidados debe... Leer el resto
Publicado el 07 junio 2011 SALUD Y BIENESTAR -
Votaciones para financiar Vida X Vida

El cortometraje Vida X Vida se encuentra en una página en la cual los proyectos más votados pasan a ser financiados. Sólo teneis que entrar en la página y... Leer el resto
Publicado el 06 junio 2011 SALUD Y BIENESTAR -
Vida X Vida. El cortometraje. Entrevista a su guionista, Jordi Rosell

Jordi Rosell La Asociación para la Lucha Contra las Enfermedades Renales (ALCER-CR) en colaboración con la productora ciudadrealeña Macro Producciones, en u... Leer el resto
Publicado el 03 junio 2011 SALUD Y BIENESTAR -
He pillado un resfriado !!

Hoy tengo un día regular. He pillado un buen resfriado. No me resfrio en todo el invierno y ahora que se acerca el buen tiempo voy yo y lo atrapo. Leer el resto
Publicado el 03 junio 2011 SALUD Y BIENESTAR -
Algunos consejos para tomarse bien la tensión arterial

Para tomarse uno mismo la tensión arterial de manera correcta, tenemos que tener presentes algunas recomendaciones para que sea una toma lo más exacta... Leer el resto
Publicado el 02 junio 2011 SALUD Y BIENESTAR -
Día 1 de junio "Día Nacional del Donante"

Hoy es el Día Nacional del Donante. Es el día de las personas generosas y solidarias que regalan vida, cuando ya no necesitan sus órganos, a otras que los... Leer el resto
Publicado el 01 junio 2011 SALUD Y BIENESTAR -
¿Qué es "E. Coli"?
¿Qué es 'E. coli? Es una bacteria común que vive en los intestinos de animales y humanos. Existen muchas cepas de 'E. coli', inofensivas en su mayoría, aunque... Leer el resto
Publicado el 31 mayo 2011 SALUD Y BIENESTAR -
Consejos para realizar una dieta correcta

Ahora llegan las prisas por perder los kilos que se acumulan en invierno y que, gracias a la ropa, se disimulan. Pero si para una persona sana no es... Leer el resto
Publicado el 30 mayo 2011 SALUD Y BIENESTAR -
José Carlos Gómez (cantante trasplantado) una perfecta fusión del pop con el...

Mas información sobre el cantante : http://www.josecarlosgomez.es/ http://www.myspace.com/josecarlosgomez Ana Leer el resto
Publicado el 28 mayo 2011 SALUD Y BIENESTAR -
La ictioterapia

Hoy he probado la ictioterapia. Tenía ganas de probar este tratamiento de pedicura natural, y mi marido y yo no hemos dudado en probarlo. ... Leer el resto
Publicado el 28 mayo 2011 SALUD Y BIENESTAR -
Campaña de prevención del cáncer de piel 2011

La AEDV (Academia Española de Dermatología y Venereología) lanza una campaña informativa a la población sobe el cáncer de piel. Los casos de melanoma están... Leer el resto
Publicado el 27 mayo 2011 SALUD Y BIENESTAR -
La dolencia que da la espalda al sexo

Los jóvenes con insuficiencia renal dejan a un lado las relaciones sexuales por los efectos que tiene en su salud: descenso del deseo, alteraciones de la... Leer el resto
Publicado el 26 mayo 2011 SALUD Y BIENESTAR -
Problemas de piel típicos del verano

Ya tenemos aquí el calor y con él vienen los problemas típicos del verano y del buen tiempo. Viene la época de ir a la playa y de los chapuzones en el agua,... Leer el resto
Publicado el 25 mayo 2011 SALUD Y BIENESTAR
